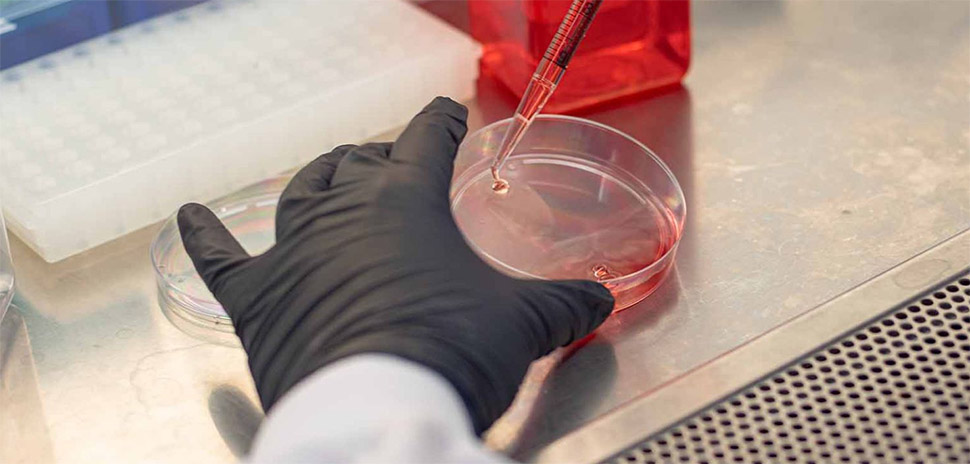

When scientists grow and engineer cells for research, those cells can be accidentally mislabeled, contaminated, or even copied without permission. The consequences are costly: industry-wide, such errors lead to billions of dollars in losses each year and put critical discoveries at risk.
A team at the University of Texas at Dallas says it has developed a solution—a way to “barcode” living cells with unique genetic fingerprints that verify their origin and make them nearly impossible to duplicate. The study was published this summer in Advanced Science.
“There are thousands of genetically engineered cell lines in use today, yet we often have no reliable way to verify their identity and origin,” said Leonidas Bleris, professor of bioengineering at UTD. “Our team has been tackling this challenge by developing innovative solutions that embed unique genetic IDs—essentially barcodes—directly into cells.”
The technique adapts a concept used in microchip security known as physical unclonable functions, or PUFs, and applies it to biology. The idea is a tamper-proof “fingerprint” embedded in a cell’s DNA that can’t be copied.

From left: Zikun Zhou, biomedical engineering doctoral student; Taek Kang, bioengineering researcher and former Eugene McDermott Graduate Fellow; and Leonidas Bleris, professor of bioengineering at UT Dallas. [Photo: UT Dallas]
UTD researchers simplified their process from two steps to one, making it easier for companies to adopt. They also built machine learning tools that can check the fingerprints more accurately.
“The machine learning-based method we developed allows us to fully utilize the space of genetic fingerprints and improve the resolution of cell-line identification,” said Taek Kang, a bioengineering researcher at UTD and co-lead author of the study.
A UT Dallas researcher uses a pipette to feed cultured mammalian cells. The team has developed a method to embed tamper-proof genetic “fingerprints” into engineered cells. [Photo: UT Dallas]
The method is patent-pending, and its commercial potential is already being pursued. To bring the technology to market, Bleris and Alexander Pertsemlidis of UT San Antonio co-founded SyntaxisBio Inc., a biotech startup supported by the National Science Foundation and a Small Business Technology Transfer grant from the National Institutes of Health.
The UTD team believes their genetic barcoding approach could help biotech firms avoid costly misidentification, protect intellectual property, and bring therapies to market faster.
“The widespread use of the gene-editing tool CRISPR has accelerated the creation of new research models,” Bleris said. “But this rapid growth has outpaced current authentication capabilities.”
Don’t miss what’s next. Subscribe to Dallas Innovates.
Track Dallas-Fort Worth’s business and innovation landscape with our curated news in your inbox Tuesday-Thursday.













